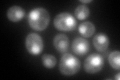
YKL210W
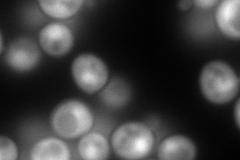
YKL210W
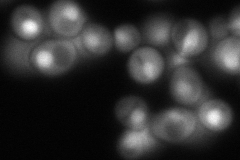
YKL210W

View description
Ubiquitin activating enzyme (E1), involved in ubiquitin-mediated protein degradation and essential for viability
Localization:
Intensity:
Fold change:
Significance:
-
C’ GFP library in SD
nucleus:cytosol186.8 -
N' NOP1pr-GFP in SD
cytosol,nucleus312.908 -
N' TEF2pr-mCherry in SD

cytosol,nucleus0 -
N' NATIVEpr-GFP in SD
below threshold155.811 -
N' TEF2pr-VC and Cyto-VN in SD

cytosol86.0844 -
C’ GFP library in SD+DTT

nucleus.cytosol262.231.4No -
C’ GFP library in SD+H2O2

nucleus.cytosol225.821.2No -
C’ GFP library in Starvation Media

nucleus,cytosol222.91.19No -
C’ GFP library on the background of Pup2-DaMP

nucleus:cytosol -
C’ GFP library on the background of CCT mutant

nucleus:cytosol227.7011.21893No
